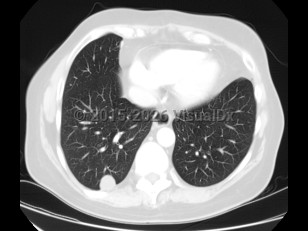

Dirofilariasis
Alerts and Notices
Important News & Links
Synopsis

Dirofilariasis is a zoonosis encountered in most parts of the world; it is caused by the nematode Dirofilaria. Cats and dogs constitute the major domestic reservoirs for this parasite; wild carnivores (foxes, muskrats, wolves) can also be infected.
Humans are accidental and dead-end hosts who can become infected by the bite of a Culex, Anopheles, Aedes, Mansonia, Psorophora, or Taeniorhynchus mosquito (depending on geographic location). There are over 30 species of Dirofilaria, and while all probably hold zoonotic potential, 4 cause most human disease: Dirofilaria repens, Dirofilaria immitis, Dirofilaria tenuis, and Dirofilaria ursi. The first 2 species account for the majority of cases. Dirofilaria repens is mostly seen in Africa, Asia, and Europe, while D. immitis is prevalent in Asia, Africa, Australia, and the Americas. Dirofilaria immitis is also known as "dog heartworm," as it causes heart disease in dogs.
The infection tends to be very localized with minimal or absent systemic symptoms. Eosinophilia may be found.
Dirofilaria is introduced into subcutaneous tissues after a mosquito bite. From there, it travels to the right ventricle and to the pulmonary arteries. A granulomatous inflammatory reaction is generated at the site of infection.
Initial symptoms may include a subcutaneous nodule, pruritic and/or painful, appearing 2-8 weeks after the mosquito bite. This nodule can reach about 1.5 inches (3.8 cm) in diameter and usually appears on an exposed body area (head, torso, limbs). Dirofilaria repens is a common cause of subcutaneous disease.
The second most common presentation is pulmonary nodules. Patients are usually asymptomatic but may present with cough, hemoptysis, fever, and chest pain. Most frequently, however, infection in these patients presents as a solitary nodule on chest radiographs, and the diagnosis is usually made on pathology (done to rule out other serious conditions; see Differential Diagnosis & Pitfalls). Dirofilaria immitis is the most common cause of pulmonary lesions, although D. repens has also been reported.
There are many reports of disease involving the eyes (conjunctiva, anterior or posterior chambers).
Infection involving the brain, liver, lymphatic system, and muscles has also been described.
Humans are accidental and dead-end hosts who can become infected by the bite of a Culex, Anopheles, Aedes, Mansonia, Psorophora, or Taeniorhynchus mosquito (depending on geographic location). There are over 30 species of Dirofilaria, and while all probably hold zoonotic potential, 4 cause most human disease: Dirofilaria repens, Dirofilaria immitis, Dirofilaria tenuis, and Dirofilaria ursi. The first 2 species account for the majority of cases. Dirofilaria repens is mostly seen in Africa, Asia, and Europe, while D. immitis is prevalent in Asia, Africa, Australia, and the Americas. Dirofilaria immitis is also known as "dog heartworm," as it causes heart disease in dogs.
The infection tends to be very localized with minimal or absent systemic symptoms. Eosinophilia may be found.
Dirofilaria is introduced into subcutaneous tissues after a mosquito bite. From there, it travels to the right ventricle and to the pulmonary arteries. A granulomatous inflammatory reaction is generated at the site of infection.
Initial symptoms may include a subcutaneous nodule, pruritic and/or painful, appearing 2-8 weeks after the mosquito bite. This nodule can reach about 1.5 inches (3.8 cm) in diameter and usually appears on an exposed body area (head, torso, limbs). Dirofilaria repens is a common cause of subcutaneous disease.
The second most common presentation is pulmonary nodules. Patients are usually asymptomatic but may present with cough, hemoptysis, fever, and chest pain. Most frequently, however, infection in these patients presents as a solitary nodule on chest radiographs, and the diagnosis is usually made on pathology (done to rule out other serious conditions; see Differential Diagnosis & Pitfalls). Dirofilaria immitis is the most common cause of pulmonary lesions, although D. repens has also been reported.
There are many reports of disease involving the eyes (conjunctiva, anterior or posterior chambers).
Infection involving the brain, liver, lymphatic system, and muscles has also been described.
Codes
ICD10CM:
B74.8 – Other filariases
SNOMEDCT:
73328005 – Infection by Dirofilaria
B74.8 – Other filariases
SNOMEDCT:
73328005 – Infection by Dirofilaria
Look For
Subscription Required
Diagnostic Pearls
Subscription Required
Differential Diagnosis & Pitfalls

To perform a comparison, select diagnoses from the classic differential
Subscription Required
Best Tests
Subscription Required
Management Pearls
Subscription Required
Therapy
Subscription Required
References
Subscription Required
Last Updated:03/23/2020